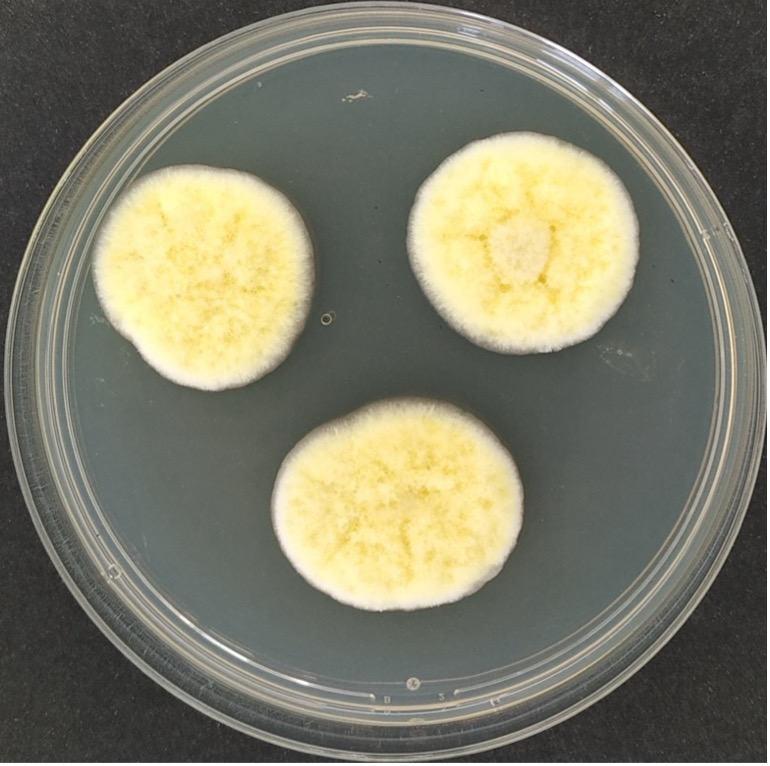
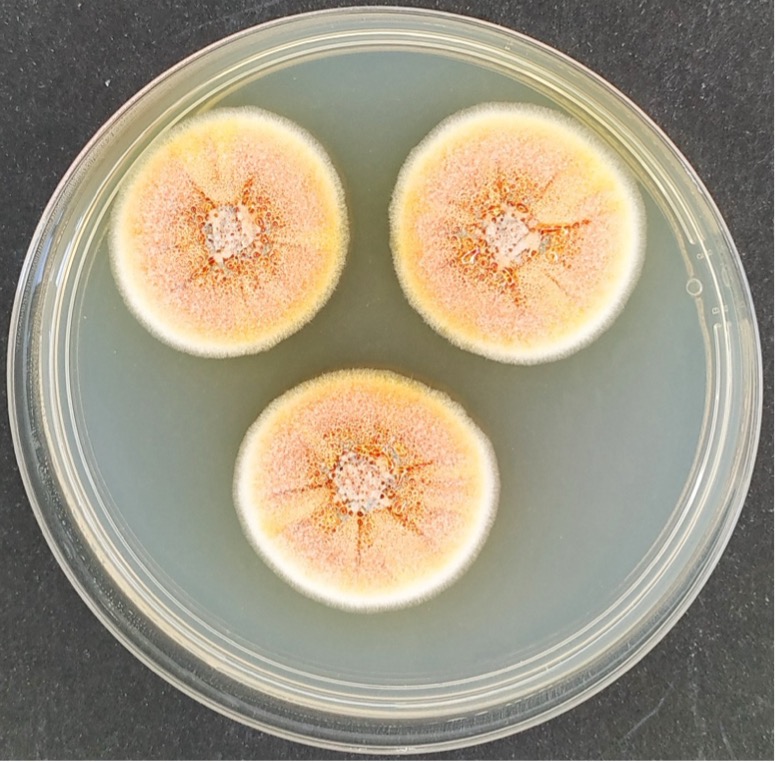

The colleciton of DISTAV ColD UNIGE
UNIGE's live fungal collection dates back to the 1970s, thanks to Professor Aurora Montemartini Corte. The collection originally included fungal strains, mostly from Antarctic aquatic environments, including marine environments. Over the years, the Genoa School of Mycology has continued to collect and preserve live fungal strains from a wide range of mycological studies, gradually expanding the collection.
The Collection today, called ColD-UNIGE, includes a vast range of microorganisms that are the subject of research at DISTAV. These are mostly filamentous fungi isolated in the Mycology Laboratory, but also yeasts from the Marine Biotechnology Laboratory and bacteria from the Microbiology Laboratory.
The only collection of its kind in Liguria, ColD-UNIGE plays a key role in the conservation of microbial biodiversity and in supporting basic and applied research at the regional, national, and international levels.
Core activities include isolation, identification, purification, and molecular analysis of strains, as well as characterization, conservation, and valorization of microbial strains. In addition to research, ColD also offers a variety of external services, such as public or private storage and/or transfer of strains; educational and/or consulting services related to biodeteriorating fungi (including areomycological analyses), pathogens, and opportunists; and selection and preparation of customized microbial inocula for use in environmental remediation and/or restoration.
The collection is also committed to professional training and development. Among its main initiatives, it organizes specialized courses in collaboration with public bodies, including the Liguria and Piedmont regions and the local health authority (ASL). These courses provide participants with the qualifications necessary to obtain the Mycologist Certificate, pursuant to Ministerial Decree 686/96.




“Strengthening the MIRRI Italian Research Infrastructure for Sustainable Bioscience and Bioeconomy”
Area ESFRI “Health and Food”, granted by the European Commission – NextGenerationEU
Code N° IR0000005